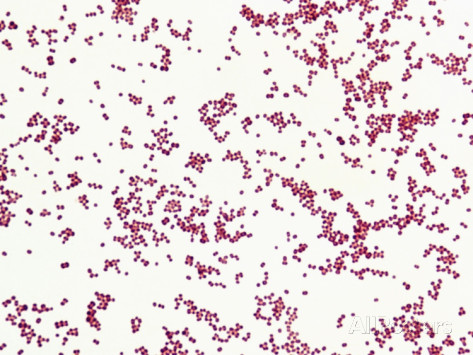

Vet Sci Parasite/Microscopic ID
5.0(1)
Studied by 61 peopleCard Sorting
1/44
Earn XP
Last updated 1:43 AM on 11/20/23
Name | Mastery | Learn | Test | Matching | Spaced | Call with Kai |
|---|
No analytics yet
Send a link to your students to track their progress
45 Terms
1
New cards
Blowfly (Family Calliphoridae)

2
New cards
Calcium oxalate crystals

3
New cards
Cat Warble (Genus Cuterebra)

4
New cards
Cocci (bacteria)
5
New cards
Coccidia (Genus Isospora or Eimeria)

6
New cards
Demodectic Mite (Genus Demodex)

7
New cards
Ear mite (Family Psoroptidae; Genus Otodectes)

8
New cards
Eosinophils

9
New cards
Epithelial cells (urine)

10
New cards
Flea Larva (Genus Ctenocephalides)

11
New cards
Flea Tapeworm Egg (Genus Dipylidium)

12
New cards
Flea Tapeworm Segment (Genus Dipylidium)

13
New cards
Flea Tapeworm (Genus Dipylidium)

14
New cards
Fleas (Genus Ctenocephalides)

15
New cards
Giardia (Genus Giardia)

16
New cards
Heartworm Adult (Genus Dirofilaria)

17
New cards
Heartworm Microfilaria (Genus Dirofilaria)

18
New cards
Hookworm Adult (Family Ancylostomatidae; Genus Ancylostoma, Uncinaria, Bunostomum or Globocephalus)

19
New cards
Hookworm Egg (Family Ancylostomatidae; Genus Ancylostoma, Uncinaria, Bunostomum, or Globocephalus)

20
New cards
Horse Bots (Genus Gasterophilus)

21
New cards
Horse Strongyles (Family Strongylidae; Genus Strongylus)

22
New cards
Lice - Biting (Order Mallophaga; Genus Bovicola or Trichodectes)

23
New cards
Lice - Sucking (Order Anoplura; Genus Linognathus or Hematopinus)

24
New cards
Liver Fluke (Class Trematoda; Genus Fasciola, Fascioloides or Dicrocoelium)

25
New cards
Mosquito Adult (Family Culicidae; Genus Anopheles, Culex or Aedes)

26
New cards
Mosquito Larva (Family Culicidae; Genus Anopheles, Culex or Aedes)

27
New cards
Neutrophils

28
New cards
Platelets

29
New cards
Red Blood cell (Mammalian)
30
New cards
Rod (bacteria)

31
New cards
Roundworm Adult (Family Ascarididae or Toxocaridae; Genus Toxocara, Toxascaris, Ascaris, Parascaris or Neoascaris)

32
New cards
Roundworm Egg (Family Ascarididae or Toxocaridae; Genus Toxocara, Toxascaris, Ascaris, Parascaris or Neoascaris)

33
New cards
Sarcoptic Mite (Family Sarcoptidae; Genus Sarcoptes or Notoedres)

34
New cards
Struvite crystals (triple magnesium phosphate)

35
New cards
Taenia Tapeworm Egg (family Taeniddae; Genus Taenia)

36
New cards
Taenia Tapeworm Segment (family Taeniddae; Genus Taenia)

37
New cards
Taenia Tapeworm (family Taeniddae; Genus Taenia)

38
New cards
American Dog Tick (Family Dermacentor; Genus variabilis)

39
New cards
Black Legged Deer Tick (Family Ixodes; Genus Scapularis)

40
New cards
Brown Dog Tick (Family Rhipicephalus; Genus Sanguineus)

41
New cards
Lonestar Tick (Family Amblyomma; Genus Americanum)

42
New cards
Whipworm Egg (Genus Trichuris)

43
New cards
Whipworm (Genus Trichuris)

44
New cards
Yeast (cytology)

45
New cards
Red Blood cell (Avian)
